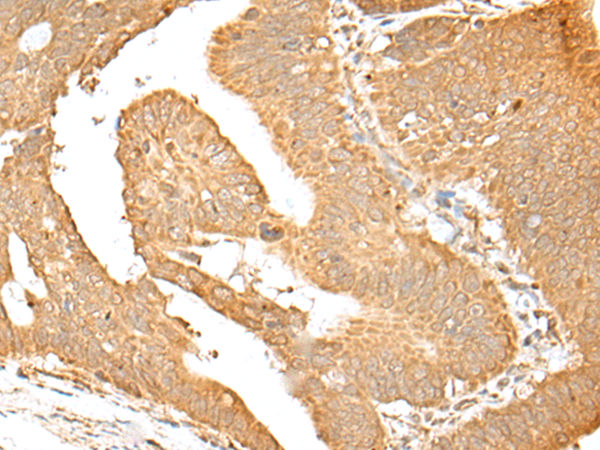
一抗

|
Background: |
This gene encodes a member of the SWI/SNF family of proteins. The encoded protein is an ATPase which is expressed in diverse tissues and contributes to the chromatin remodeling complex that is involved in transcription. The protein may also play a role in DNA damage, growth inhibition and apoptosis of cancer cells. Alternative splicing results in multiple transcript variants. |
|
Applications: |
ELISA, IHC |
|
Name of antibody: |
SMARCA1 |
|
Immunogen: |
Synthetic peptide of human SMARCA1 |
|
Full name: |
SWI/SNF related, matrix associated, actin dependent regulator of chromatin, subfamily a, member 1 |
|
Synonyms: |
SWI; ISWI; SWI2; SNF2L; SNF2L1; SNF2LB; SNF2LT; NURF140 |
|
SwissProt: |
P28370 |
|
ELISA Recommended dilution: |
5000-10000 |
|
IHC positive control: |
Human liver cancer and human gastric cancer |
|
IHC Recommend dilution: |
25-100 |


 購(gòu)物車
購(gòu)物車 幫助
幫助
 021-54845833/15800441009
021-54845833/15800441009